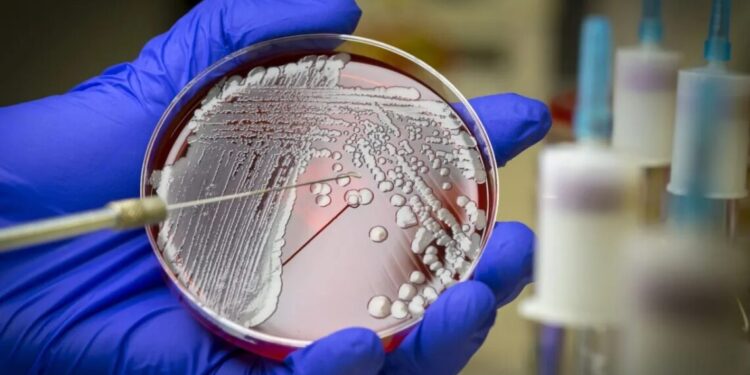
Conheça as 15 bactérias mais perigosas para a saúde humana, segundo a OMS

A OMS (Organização Mundial da Saúde) divulgou na sexta-feira (17) uma atualização na lista de Patógenos Bacterianos Prioritários 2024, que apresenta 15 famílias de bactérias que oferecem riscos à saúde humana por serem resistentes a antibióticos.
A lista divide as bactérias em categorias críticas, altas e médias de priorização, fornecendo orientações sobre o desenvolvimento de tratamentos novos e necessários para impedir a propagação de bactérias com resistência a antibióticos.
A lista foi publicada pela primeira vez em 2017, ano em que a ameaça da resistência antimicrobiana se intensificou, de acordo com Yukiko Nakatani, diretora-geral adjunta de resistência antimicrobiana da OMS. Agora, a atualização da lista poderá “mapear a carga global de bactérias resistentes aos medicamentos e avaliar o seu impacto na saúde pública”, segundo a especialista.
“Esta lista é fundamental para orientar o investimento e lidar com o pipeline de antibióticos e a crise de acesso”, afirma Nakatani, em comunicado divulgado à imprensa.
O que é resistência antimicrobiana?
A resistência antimicrobiana acontece quando bactérias, vírus, fungos e parasitas deixam de responder aos medicamentos, tornando as pessoas mais doentes e aumentando o risco de propagação de doenças e de morte.
PUBLICIDADE
No caso das bactérias, esse fenômeno é conhecido como resistência a antibióticos e os microrganismos que apresentam essa resistência são chamados de “superbactérias“.
De acordo com a OMS, a resistência é motivada, em grande parte, pelo uso indevido e excessivo de antibióticos por parte dos pacientes.
“A resistência antimicrobiana põe em risco a nossa capacidade de tratar eficazmente infecções de alto impacto, como a tuberculose, levando a doenças graves e ao aumento das taxas de mortalidade”, afirmou Jérôme Salomon, diretor-geral adjunto da OMS para a Cobertura Universal de Saúde, Doenças Transmissíveis e Não Transmissíveis.
Quais são as bactérias resistentes a antibióticos da lista da OMS?
Entre os agentes patogênicos que foram classificados como prioridade crítica estão as bactérias gram-negativas resistentes aos antibióticos de último recurso e o Mycobacterium tuberculosis resistente ao antibiótico rifampicina. De acordo com a OMS, esses microrganismos apresentam ameaças globais devido à sua elevada carga e capacidade de resistir ao tratamento e de espalhar essa resistência para outras bactérias.
Já entre os agentes patógenos de alta prioridade, estão a Salmonella e Shigella, frequentemente encontradas em alimentos contaminados malcozidos. Segundo a OMS, elas são potencialmente perigosas em países de baixa e média renda, junto com a Pseudomonas aeruginosa e o Staphylococcus aureus.
Outros agentes de alta prioridade são a Neisseria gonorrhoeae e Enterococcus faecium, que, na visão da entidade, apresentam desafios únicos de saúde pública, incluindo infecções persistentes e resistência a múltiplos antibióticos, o que aumenta a necessidade de intervenções de saúde pública.
Já entre os agentes patogênicos de prioridade média incluem os estreptococos dos grupos A e B, como Streptococcus pneumoniae e Haemophilus influenzae. Segundo a OMS, esses agentes requerem maior atenção, especialmente em populações vulneráveis, incluindo populações pediátricas e idosas, principalmente em locais com recursos limitados.
A lista atualizada também enfatiza a necessidade de uma abordagem abrangente de saúde pública para resistência antimicrobiana, incluindo o acesso universal a medidas de qualidade e acessíveis para prevenção, diagnóstico e tratamento adequado de infecções, conforme descrito em documento da OMS.
Veja, abaixo, a lista completa de bactérias resistentes à antibióticos que aderiram a lista de 2024:
Prioridade crítica:
- Acinetobacter baumannii, resistente a carbapenem;
- Enterobacterales, resistentes às cefalosporinas de terceira geração; e
- Enterobacterales, resistentes a carbapenêmicos;
- Mycobacterium tuberculosis, resistente à rifampicina.
Prioridade máxima:
- Salmonella Typhi, resistente às fluoroquinolonas;
- Shigella spp., resistente a fluoroquinolonas;
- Enterococcus faecium, resistente à vancomicina;
- Pseudomonas aeruginosa, resistente a carbapenêmicos;
- Salmonella não tifóide, resistente às fluoroquinolonas;
- Neisseria gonorrhoeae, resistente à cefalosporina e/ou fluoroquinolona de terceira geração;
- Staphylococcus aureus, resistente à meticilina.
Prioridade média:
- Estreptococos do grupo A, resistentes a macrolídeos;
- Streptococcus pneumoniae, resistente a macrolídeos;
- Haemophilus influenzae, resistente à ampicilina;
- Estreptococos do grupo B, resistentes à penicilina.